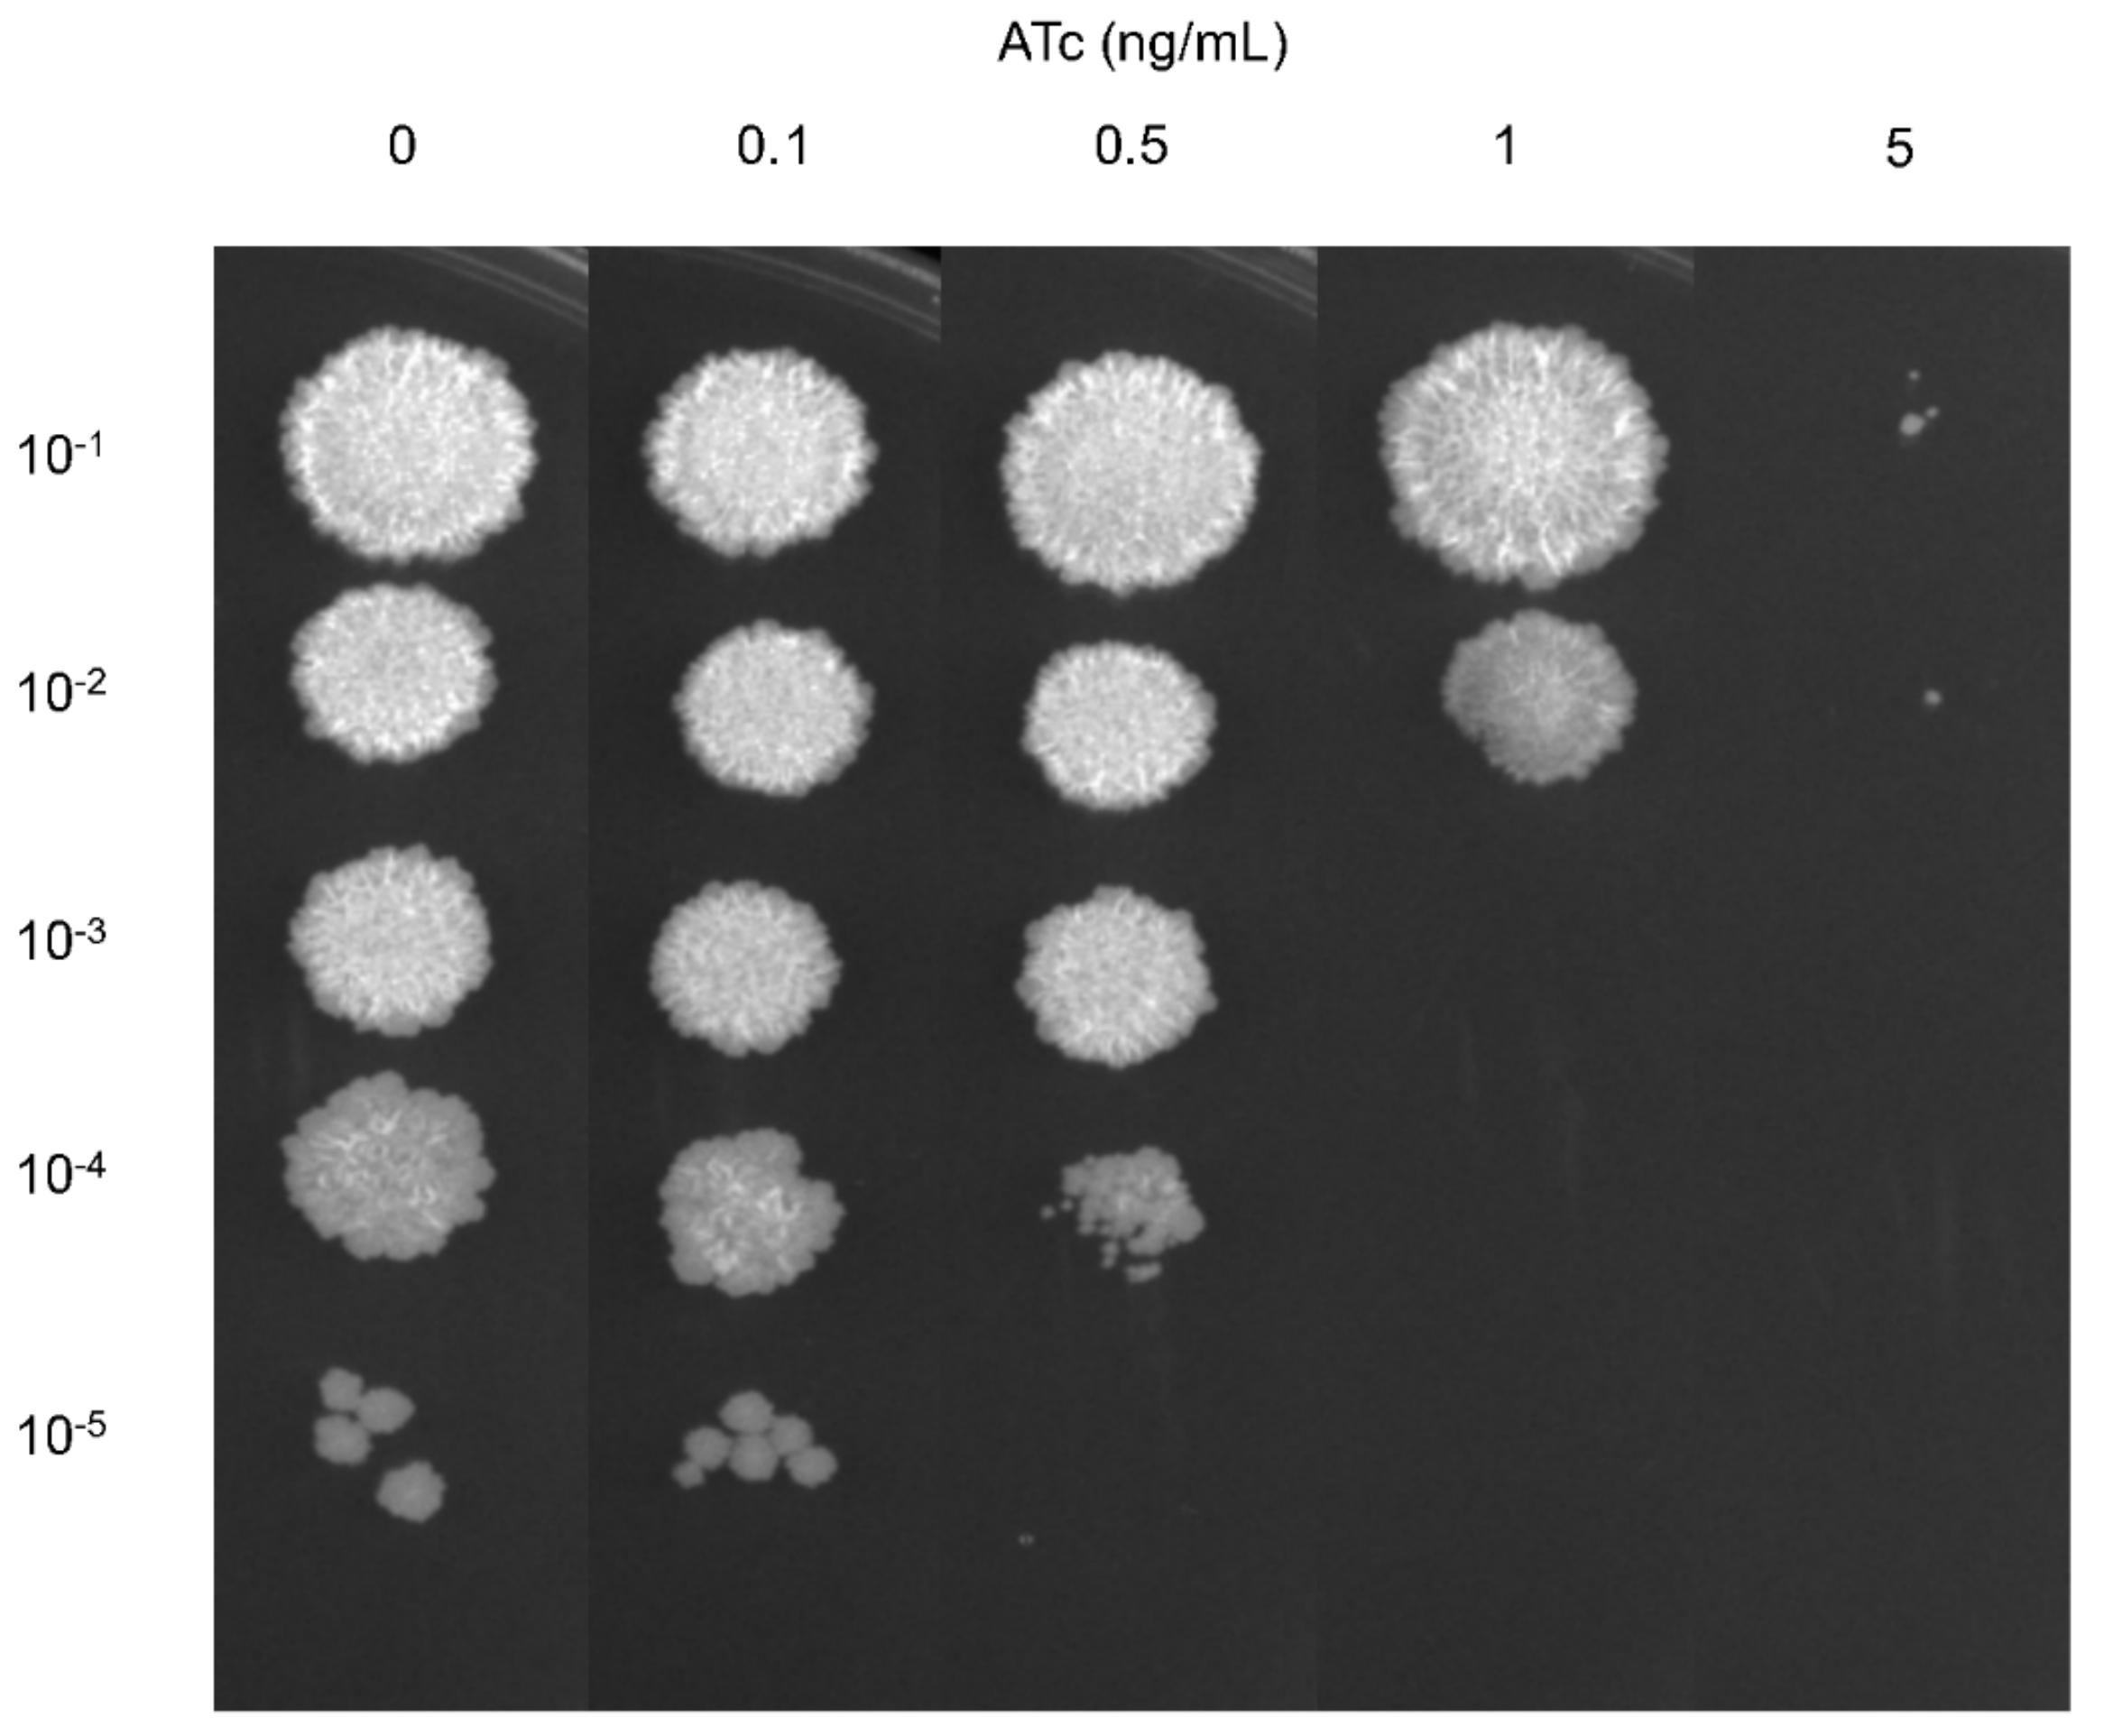
Antibiotics 13 00483 g001

CRISPR Interference-Mediated Silencing of the mmpL3 Gene in Mycobacterium smegmatis and Its Impact on Antimicrobial Susceptibility
Abstract
1. Introduction
2. Results
2.1. CRISPRi Targeting of the mmpL3 Gene Impacts M. smegmatis Growth
2.2. mmpL3 Gene Expression in the Presence and Absence of ATc
2.3. Growth Curve and Viability of mmpL3_KD M. smegmatis at Different ATc Concentrations
2.4. Resensitization of the mmpL3_KD M. smegmatis Strain to Antimicrobial Agents
3. Discussion
4. Materials and Methods
4.1. Bacterial Growth and Culture Conditions
4.2. Construction of sgRNA Expression Plasmids and mmpL3_KD Strains
4.3. Determination of the Essentiality of the mmpL3 Gene in M. smegmatis
4.4. Bacterial Growth Curve and Viability Count
4.5. Determination of the Minimal Inhibitory Concentration and Mycobacterial Viability
4.6. RNA Extraction, cDNA Synthesis, and RT-qPCR
4.7. Statistical Analysis
Supplementary Materials
Author Contributions
Funding
Institutional Review Board Statement
Informed Consent Statement
Data Availability Statement
Conflicts of Interest
References
- Xu, Z.; Meshcheryakov, V.A.; Poce, G.; Chng, S.-S. MmpL3 is the flippase for mycolic acids in mycobacteria. Proc. Natl. Acad. Sci. USA 2017, 114, 7993–7998. [Google Scholar] [CrossRef]
- Domenech, P.; Reed, M.B.; Barry, C.E. Contribution of the Mycobacterium tuberculosis MmpL Protein Family to Virulence and Drug Resistance. Infect. Immun. 2005, 73, 3492–3501. [Google Scholar] [CrossRef]
- Sacksteder, K.A.; Protopopova, M.; Barry, C.E.; Andries, K.; Nacy, C.A. Discovery and development of SQ109: A new antitubercular drug with a novel mechanism of action. Future Microbiol. 2012, 7, 823–837. [Google Scholar] [CrossRef]
- Nikonenko, B.V.; Protopopova, M.; Samala, R.; Einck, L.; Nacy, C.A. Drug Therapy of Experimental Tuberculosis (TB): Improved Outcome by Combining SQ109, a New Diamine Antibiotic, with Existing TB Drugs. Antimicrob. Agents Chemother. 2007, 51, 1563–1565. [Google Scholar] [CrossRef]
- Li, W.; Sanchez-Hidalgo, A.; Jones, V.; de Moura, V.C.; North, E.J.; Jackson, M. Synergistic Interactions of MmpL3 Inhibitors with Antitubercular Compounds In Vitro. Antimicrob. Agents Chemother. 2017, 61, e02399-16. [Google Scholar] [CrossRef]
- Dupont, C.; Viljoen, A.; Dubar, F.; Blaise, M.; Bernut, A.; Pawlik, A.; Bouchier, C.; Brosch, R.; Guérardel, Y.; Lelièvre, J.; et al. A new piperidinol derivative targeting mycolic acid transport in Mycobacterium abscessus. Mol. Microbiol. 2016, 101, 515–529. [Google Scholar] [CrossRef]
- WHO. WHO Consolidated Guidelines on Tuberculosis: Module 4: Treatment-Drug-Susceptible Tuberculosis Treatment; World Health Organization: Geneva, Switzerland, 2022. [Google Scholar]
- Daley, C.L.; Iaccarino, J.M.; Lange, C.; Cambau, E.; Wallace, R.J., Jr.; Andrejak, C.; Böttger, E.C.; Brozek, J.; Griffith, D.E.; Guglielmetti, L.; et al. Treatment of Nontuberculous Mycobacterial Pulmonary Disease: An Official ATS/ERS/ESCMID/IDSA Clinical Practice Guideline. Clin. Infect. Dis. 2020, 71, e1–e36. [Google Scholar] [CrossRef]
- Quan, S.; Imai, T.; Mikami, Y.; Yazawa, K.; Dabbs, E.R.; Morisaki, N.; Iwasaki, S.; Hashimoto, Y.; Furihata, K. ADP-Ribosylation as an intermediate step in inactivation of rifampin by a mycobacterial gene. Antimicrob. Agents Chemother. 1999, 43, 181–184. [Google Scholar] [CrossRef]
- Quan, S.; Venter, H.; Dabbs, E.R. Ribosylative inactivation of rifampin by Mycobacterium smegmatis is a principal contributor to its low susceptibility to this antibiotic. Antimicrob. Agents Chemother. 1997, 41, 2456–2460. [Google Scholar] [CrossRef]
- Hetherington, S.V.; Watson, A.S.; Patrick, C.C. Sequence and analysis of the rpoB gene of Mycobacterium smegmatis. Antimicrob. Agents Chemother. 1995, 39, 2164–2166. [Google Scholar] [CrossRef]
- Flores, A.R.; Parsons, L.M.; Pavelka, M.S. Genetic analysis of the β-lactamases of Mycobacterium tuberculosis and Mycobacterium smegmatis and susceptibility to β-lactam antibiotics. Microbiology 2005, 151, 521–532. [Google Scholar] [CrossRef]
- Chen, P.; Gearhart, J.; Protopopova, M.; Einck, L.; Nacy, C.A. Synergistic interactions of SQ109, a new ethylene diamine, with front-line antitubercular drugs in vitro. J. Antimicrob. Chemother. 2006, 58, 332–337. [Google Scholar] [CrossRef]
- Stec, J.; Onajole, O.K.; Lun, S.; Guo, H.; Merenbloom, B.; Vistoli, G.; Bishai, W.R.; Kozikowski, A.P. Indole-2-carboxamide-based MmpL3 Inhibitors Show Exceptional Antitubercular Activity in an Animal Model of Tuberculosis Infection. J. Med. Chem. 2016, 59, 6232–6247. [Google Scholar] [CrossRef]
- Li, W.; Obregón-Henao, A.; Wallach, J.B.; North, E.J.; Lee, R.E.; Gonzalez-Juarrero, M.; Schnappinger, D.; Jackson, M. Therapeutic Potential of the Mycobacterium tuberculosis mycolic acid transporter, MmpL3. Antimicrob. Agents Chemother. 2016, 60, 5198–5207. [Google Scholar] [CrossRef]
- McNeil, M.B.; Dennison, D.; Parish, T. Mutations in MmpL3 alter membrane potential, hydrophobicity and antibiotic susceptibility in Mycobacterium smegmatis. Microbiology 2017, 163, 1065–1070. [Google Scholar] [CrossRef]
- McNeil, M.B.; Cook, G.M. Utilization of CRISPR interference to validate MmpL3 as a drug target in Mycobacterium tuberculosis. Antimicrob. Agents Chemother. 2019, 63, e00629-19. [Google Scholar] [CrossRef]
- Rock, J.M.; Hopkins, F.F.; Chavez, A.; Diallo, M.; Chase, M.R.; Gerrick, E.R.; Pritchard, J.R.; Church, G.M.; Rubin, E.J.; Sassetti, C.M.; et al. Programmable transcriptional repression in mycobacteria using an orthogonal CRISPR interference platform. Nat. Microbiol. 2017, 2, 16274. [Google Scholar] [CrossRef]
- Faulkner, V.; Cox, A.A.; Goh, S.; van Bohemen, A.; Gibson, A.J.; Liebster, O.; Wren, B.W.; Willcocks, S.; Kendall, S.L. Re-sensitization of Mycobacterium smegmatis to rifampicin using CRISPR interference demonstrates its utility for the study of non-essential drug resistance traits. Front. Microbiol. 2020, 11, 619427. [Google Scholar] [CrossRef]
- Kurepina, N.; Chen, L.; Composto, K.; Rifat, D.; Nuermberger, E.L.; Kreiswirth, B.N. CRISPR inhibition of essential of peptidoglycan biosynthesis genes in Mycobacterium abscessus and its impact on β-lactam susceptibility. Antimicrob. Agents Chemother. 2022, 66, e0009322. [Google Scholar] [CrossRef]
- Wong, A.I.; Rock, J.M. CRISPR Interference (CRISPRi) for Targeted Gene Silencing in Mycobacteria. In Mycobacteria Protocols; Parish, T., Kumar, A., Eds.; Springer: New York, NY, USA, 2021; pp. 343–364. [Google Scholar]
- Degiacomi, G.; Benjak, A.; Madacki, J.; Boldrin, F.; Provvedi, R.; Palù, G.; Kordulakova, J.; Cole, S.T.; Manganelli, R. Essentiality of mmpL3 and impact of its silencing on Mycobacterium tuberculosis gene expression. Sci. Rep. 2017, 7, 43495. [Google Scholar] [CrossRef]
- Varela, C.; Rittmann, D.; Singh, A.; Krumbach, K.; Bhatt, K.; Eggeling, L.; Besra, G.S.; Bhatt, A. MmpL genes are associated with mycolic acid metabolism in mycobacteria and corynebacteria. Chem. Biol. 2012, 19, 498–506. [Google Scholar] [CrossRef] [PubMed]
- Boudehen, Y.-M.; Tasrini, Y.; Aguilera-Correa, J.J.; Alcaraz, M.; Kremer, L. Silencing essential gene expression in Mycobacterium abscessus during infection. Microbiol. Spectr. 2023, 11, e0283623. [Google Scholar] [CrossRef] [PubMed]
- Tahlan, K.; Wilson, R.; Kastrinsky, D.B.; Arora, K.; Nair, V.; Fischer, E.; Barnes, S.W.; Walker, J.R.; Alland, D.; Barry, C.E.; et al. SQ109 Targets MmpL3, a Membrane Transporter of Trehalose Monomycolate Involved in Mycolic Acid Donation to the Cell Wall Core of Mycobacterium tuberculosis. Antimicrob. Agents Chemother. 2012, 56, 1797–1809. [Google Scholar] [CrossRef] [PubMed]
- Lun, S.; Guo, H.; Onajole, O.K.; Pieroni, M.; Gunosewoyo, H.; Chen, G.; Tipparaju, S.K.; Ammerman, N.C.; Kozikowski, A.P.; Bishai, W.R. Indoleamides are active against drug-resistant Mycobacterium tuberculosis. Nat. Commun. 2013, 4, 2907. [Google Scholar] [CrossRef] [PubMed]
- Evans, J.C.; Mizrahi, V. The application of tetracyclineregulated gene expression systems in the validation of novel drug targets in Mycobacterium tuberculosis. Front. Microbiol. 2015, 6, 812. [Google Scholar] [CrossRef]
- CLSI. Susceptibility Testing of Mycobacteria, Nocardia spp., and Other Aerobic Actinomycetes, 3rd ed.; CLSI Standard M24; Clinical and Laboratory Standads Institute: Wayne, PA, USA, 2018. [Google Scholar]
- Rustad, T.R.; Roberts, D.M.; Liao, R.P.; Sherman, D.R. Isolation of mycobacterial RNA. In Mycobacteria Protocols, 2nd ed.; Parish, T., Brown, A.C., Eds.; Humana Press: Totowa, NJ, USA, 2009; pp. 13–22. [Google Scholar]
- Di Somma, A.; Caterino, M.; Soni, V.; Agarwal, M.; di Pasquale, P.; Zanetti, S.; Molicotti, P.; Cannas, S.; Nandicoori, V.K.; Duilio, A. The bifunctional protein GlmU is a key factor in biofilm formation induced by alkylating stress in Mycobacterium smegmatis. Res. Microbiol. 2019, 170, 171–181. [Google Scholar] [CrossRef]

Disclaimer/Publisher’s Note: The statements, opinions and data contained in all publications are solely those of the individual author(s) and contributor(s) and not of MDPI and/or the editor(s). MDPI and/or the editor(s) disclaim responsibility for any injury to people or property resulting from any ideas, methods, instructions or products referred to in the content. |
© 2024 by the authors. Licensee MDPI, Basel, Switzerland. This article is an open access article distributed under the terms and conditions of the Creative Commons Attribution (CC BY) license (https://creativecommons.org/licenses/by/4.0/).
Share and Cite
Yuliani, Y.; Ilmi, A.F.N.; Petsong, S.; Sawatpanich, A.; Chirakul, S.; Chatsuwan, T.; Palaga, T.; Rotcheewaphan, S. CRISPR Interference-Mediated Silencing of the mmpL3 Gene in Mycobacterium smegmatis and Its Impact on Antimicrobial Susceptibility. Antibiotics 2024, 13, 483. https://doi.org/10.3390/antibiotics13060483
Yuliani Y, Ilmi AFN, Petsong S, Sawatpanich A, Chirakul S, Chatsuwan T, Palaga T, Rotcheewaphan S. CRISPR Interference-Mediated Silencing of the mmpL3 Gene in Mycobacterium smegmatis and Its Impact on Antimicrobial Susceptibility. Antibiotics. 2024; 13(6):483. https://doi.org/10.3390/antibiotics13060483
Chicago/Turabian StyleYuliani, Yonita, Azizah Fitriana Nurul Ilmi, Suthidee Petsong, Ajcharaporn Sawatpanich, Sunisa Chirakul, Tanittha Chatsuwan, Tanapat Palaga, and Suwatchareeporn Rotcheewaphan. 2024. "CRISPR Interference-Mediated Silencing of the mmpL3 Gene in Mycobacterium smegmatis and Its Impact on Antimicrobial Susceptibility" Antibiotics 13, no. 6: 483. https://doi.org/10.3390/antibiotics13060483
APA StyleYuliani, Y., Ilmi, A. F. N., Petsong, S., Sawatpanich, A., Chirakul, S., Chatsuwan, T., Palaga, T., & Rotcheewaphan, S. (2024). CRISPR Interference-Mediated Silencing of the mmpL3 Gene in Mycobacterium smegmatis and Its Impact on Antimicrobial Susceptibility. Antibiotics, 13(6), 483. https://doi.org/10.3390/antibiotics13060483

